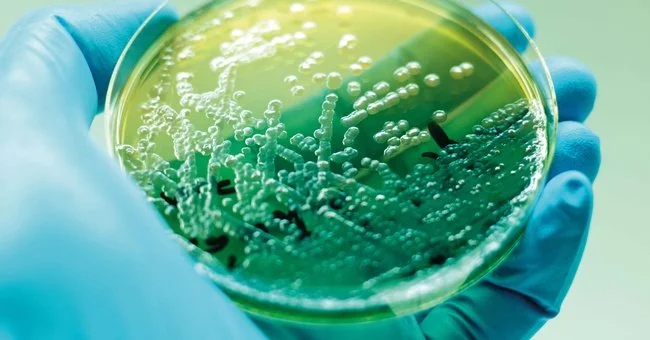
Artemisia annua bei Viruserkrankungen

Malaria & Artemisia annua
Artemisia annua und Malaria – eine systemunabhängige wissenschaftliche Analyse. Von der 2000-jährigen Tradition in TCM, Ayurveda und Afrika über ACTs als WHO-Goldstandard bis zur 45-fach höheren Bioverfügbarkeit von Ganzpflanzenextrakten und der Fähigkeit, Artemisinin-Resistenzen zu verlangsamen. Mit aktuellen Studien (Weathers 2023, Elfawal 2015) und allen relevanten DOIs.
Artemisia annua in der Onkologie
Artemisia annua in der Onkologie – systemunabhängige Analyse für Ärzte und Wissenschaftler. Von Ferroptose-Induktion und Eisen-Selektivität über Phase-I/II-Studien (Glioblastom, Brustkrebs, CIN) bis zur 45-fach höheren Bioverfügbarkeit von Ganzpflanzenextrakten und synergistischen Flavonoiden. Mit Fokus auf Artesunat als Adjuvans bei Glioblastom und Multi-Target-Mechanismen (Weathers 2023, Efferth et al.).
Artemisia annua bei Borreliose und Babesiose
Artemisia annua bei Borreliose und Babesiose – systemunabhängige wissenschaftliche Analyse. Von ROS-generierter Membranzerstörung und Anti-Persister-Wirkung (Johns Hopkins) über TCM-Protokolle, ayurvedische Kombinationen mit Andrographis und Ashwagandha bis hin zu klinischen Erfahrungen mit Babesiose-Koinfektionen. Mit Fokus auf persistente Borrelia-Formen, PTLDS und synergistische Ganzpflanzen-Effekte.
Artemisia annua bei Parasiten
Artemisia annua bei Parasiten – systemunabhängige wissenschaftliche Analyse zu Protozoen (Leishmania, Toxoplasma, Giardia), Trematoden (Schistosoma), Nematoden und vernachlässigten Tropenkrankheiten. Mit Fokus auf eisen-aktivierten ROS-Mechanismus, klinischer Evidenz bei Leishmaniose und Schistosomiasis sowie synergistischen Kombinationen mit Praziquantel, Amphotericin B und ayurvedischen Kräutern (Neem, Vidanga).
Artemisia annua bei Viruserkrankungen
Artemisia annua bei Viruserkrankungen – umfassende Analyse antiviraler Wirkung bei HIV, COVID-19, Herpesviren (CMV, HSV, EBV), Influenza, Hepatitis und HPV. Mit Fokus auf ROS-Mechanismus, NF-κB-Hemmung, Ganzpflanzen-Bioverfügbarkeit, klinischen Studien zu Artesunat bei CMV und topischem Artesunat bei HPV/CIN sowie TCM- und Ayurveda-Protokollen.
Artemisia annua bei Autoimmunerkrankungen
Artemisia annua bei Autoimmunerkrankungen – systemunabhängige Analyse zu RA, SLE, Morbus Crohn, Sjögren, MS und Psoriasis. Mit Fokus auf NF-κB-Hemmung, Treg/Th17-Balancierung, B-Zell-Suppression und klinischem RCT (Yang 2017, n=159). Synergien mit Boswellia, Guduchi und Harpagophytum sowie mechanistische Konvergenz aus TCM, Ayurveda und schulmedizinischer Forschung.
Artemisia annua bei Diabetes mellitus und metabolischem Syndrom
Artemisia annua bei Diabetes mellitus und metabolischem Syndrom – systemunabhängige Analyse antidiabetischer Mechanismen (AMPK-Aktivierung, hIAPP-Disaggregation, Beta-Zell-Schutz) und diabetischer Komplikationen (Nephropathie, Retinopathie, NAFLD). Mit präklinischer Evidenz aus Tiermodellen, Primatenstudien und Humankultur-Experimenten sowie ethnotherapeutischen Konvergenzen aus TCM, Ayurveda und Afrika.
Artemisia annua bei Magen-Darm-Erkrankungen
Artemisia annua bei Magen-Darm-Erkrankungen – klinische und präklinische Evidenz zu Morbus Crohn, Colitis ulcerosa, H. pylori, NAFLD und intestinalen Parasiten. Mit drei RCTs (u. a. 65% Remission bei Morbus Crohn unter Wermut), WFAS-Leitlinie und pantraditioneller Konvergenz aus TCM, Ayurveda, Afrika und Europa.
Artemisia annua in der Veterinärmedizin
Artemisia annua in der Veterinärmedizin – antiparasitäre Anwendungen bei Hunden (Leishmaniose, Babesiose), Pferden (Piroplasmose), Nutztieren, Aquakultur und Exoten. Mit klinischen Belegen zu Artesunat bei Caniner Leishmaniose, Dreifach-Protokoll bei Babesia gibsoni und One-Health-Perspektive zu Zoonosen und Anthelminthika-Resistenz.
Artemisinin in experimentellen Forschungsfeldern: Neurologie (Parkinson, Alzheimer, Schlaganfall), antivirale Wirkung (SARS-CoV-2, Herpesviren), Seneszenz/Senolyse, PCOS (Science 2024, LONP1-CYP11A1), Dermatologie und Formulierungsinnovationen. Mit mechanistischer Dualität von ROS/Ferroptose und protektiven Signalwegen (NRF2, SIRT1, AMPK).